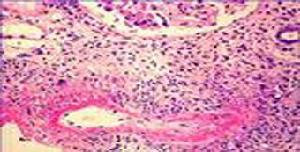
變應性皮膚結節性血管炎

流行病學
本病多發生於中青年女性。男女之比約為1∶5,平均發病年齡為30歲。發病有明顯的季節性,極大多數是春末夏初發病,盛夏較重,秋後減輕冬天消退或殘留無明顯自覺症狀的結節損害,次年又復發作。病因
本病病因不明部分患者有明確的結核病史或靜止的結核病灶,結核菌素皮膚試驗可呈強陽性,抗結核藥物治療有較好效果,提示結核過敏可能是本病的發病因素之一;少部分患者發病前後幾天有發熱咽痛或扁桃體炎,以及抗“O”升高,所以其發病又可能與鏈球菌感染過敏有關;但大部分病例未能發現與發病有關的因素。發病機制
變應性皮膚結節性血管炎
變應性皮膚結節性血管炎病變主要在真皮網狀層至皮下脂肪小葉內及其間隔間,以血管病變為主伴以肉芽腫樣或肉芽腫性結節和組織壞死。
1.血管炎主要受累的是毛細血管和細血管,少數為小動脈和靜脈以及其滋養血管,而汗腺周圍毛細血管叢幾乎全部發病。病變呈節段性分布。毛細血管和細血管特別是靜脈,其管壁水腫少許嗜伊紅性物質沉積致管壁結構模糊,突出的是內皮細胞肥大和增生,輕者核距縮短以至核重疊。或呈卵圓形和圓形,向腔內突出顯著者可有管腔狹窄或閉塞。自縱切面觀,內皮細胞呈索狀排列,橫切面觀則為內皮細胞團。滋養血管病變與毛細血管和細靜脈相似。小靜脈的內皮細胞病變較細靜脈為輕,管壁肌束因水腫而分離,有時分散成片狀;小動脈環狀肌因水腫致張力增高,排列緊密似樹輪狀,而內皮細胞病變則更輕些。偶見小動脈和小靜脈腔內血栓形成和再通。管壁內以淋巴細胞浸潤為主,無中性粒細胞及其碎裂核。
2.肉芽腫和肉芽腫樣結節在脂肪小葉內,少數為由組織細胞形成的大小不一的肉芽腫性結節多伴數量不等的多核巨細胞;多數是結節中央隱約可見的毛細血管或細血管輪廓,由於增生內皮細胞聚集成團,管腔消失,難以看到紅細胞。網狀纖維染色能顯示結節內血管輪廓,UEA和F8染色顯示結節中央為內皮細胞,Lys和α1-AT染色顯示結節外圍為組織細胞於是前者為真正肉芽腫,而後者為肉芽腫樣結節。兩種結節中均混有淋巴細胞,無上皮樣細胞和Langerhans巨細胞。
3.組織壞死脂肪小葉內呈輕度炎性反應,少數脂肪細胞變性,進而溶解以致破壞呈大小不一的腔隙;多數是大小不一的壞死灶,組織結構模糊進而壞死成為嗜紅色的細顆粒狀物質其中細血管輪廓仍隱約可見。大片壞死灶邊緣細動、靜脈管壁部分或完全壞死而破裂出血,致壞死灶內有較多紅細胞、淋巴細胞及尚有數量不等的中性粒細胞及其碎裂的核塵,偶見少許嗜酸粒細胞。小葉間隔結締組織為一般性炎症,真皮乳頭及表皮正常。
臨床表現
變應性皮膚結節性血管炎變應性皮膚結節性血管炎損害均先見於兩小腿,尤其是小腿的下2/3,呈散在分布不限於伸面或屈面在反覆發作過程中逐漸累及大腿和臀部,偶有累及前臂者,以大腿下部兩側為多。患者先感局部疼痛和壓痛,而後觸及皮下結節,數目常在10個以內,當其他部位受累時,不僅損害數目增多,並因部位不同,損害形態亦稍有變異。一般約為蠶豆至楊梅大小,邊緣可觸及,中等硬度。初發損害較小而位置較深,故多呈膚色,或為淡紅色至鮮紅色,隨著持續時間延長,紅色可加深。在3~4周內,紅色先退,殘留輕度色素沉著斑而結節損害完全消退則較晚些有一種比較特徵的損害,其持續時間較長,較前述損害稍大些,呈紫紅或暗紅色,中央皮膚光滑發亮,甚至脫屑,或有柔軟感,但從不破潰,吸收後亦無皮膚萎縮凹陷現象。臀部和大腿損害位置均較深,一般較硬,皮膚不紅或呈淡紅色,多數只可觸及外踝後損害為扁平狀的圓形硬結,皮膚顏色為淡紅,周圍組織水腫明顯所有損害均散在分布,少見擴大融合傾向者。全身性症狀依發病緩急而不同一般是睏倦不適或食欲不振。多數病例不發熱,少數病例下午低熱,勞累後升高;或有在結節發作之前後幾天內高熱的較特別的是少數患者午後畏寒甚至寒戰,繼以發熱,午夜出汗退熱,次晨如常。無持續高熱病例。在損害發作期下肢酸軟無力,肌肉脹痛。若損害數目較多,小腿下部可出現輕度水腫。四肢大關節遊走性疼痛,以膝關節為多,無紅腫及功能障礙。
併發症:
無明顯臟器受累症狀和體徵。
診斷
 變應性皮膚結節性血管炎
變應性皮膚結節性血管炎2.損害在臀部以下,主要是小腿。
3.基本損害為皮下結節,兩側分布,不限於小腿伸或屈面。
4.季節性的反覆發作,不破潰。
5.全身性症狀少,無其他系統受累症狀和體徵。
6.除結核病灶外,無其他明確的原因和誘因。
7.無網狀青斑和靜脈曲張等併發症。
鑑別診斷:
下肢炎性皮下結節是致病因素引起組織病變後的一種損害表現形式,可見於多種疾病,其性質可不同而形態則多無顯著差異,故不易鑑別發生皮下結節損害的疾病中,常見的是Behcet綜合徵少見的尚有血栓性靜脈炎、風濕病、麻風、肉樣瘤結節性脂膜炎深部紅斑狼瘡某些腫痛和結節性多動脈炎等疾病在這些疾病中皮下結節僅是其系統性損害之一其性質當不同於結節性紅斑,故診斷應以系統性疾病為主,按其形態可稱為各病的結節性紅斑樣損害。
另一類是以炎性皮下結節為主要臨床表現的皮膚病,主要有結節性紅斑、硬紅斑和結節性血管炎。目前對結節性血管炎的認識是比較模糊和混亂的有進一步研究的必要。還有少數病例發生下肢炎性皮下結節損害,往往需經多年隨訪和仔細觀察才能明確診斷。
檢查
實驗室檢查:血、尿常規及肝腎功能檢查無異常;部分病例抗“O”、血沉和黏蛋白值升高;IgGIgA值一般正常;C3或CIC值偏低或略高於正常;淋巴細胞轉化試驗值一般偏低;IL-2值偏低;NK細胞值正常;OT試驗(1∶10000),50%病例為+++~++++。
其它輔助檢查:
胸部X線攝片部分病例有陳舊性肺結核,偶有活動性肺結核。
治療
由於病變主要在下肢,除藥物治療外對病情較重者,應減少站立和行走可以縮短病程,減少痛苦,提高療效。1.有結核因素病例套用抗結核藥物治療,如口服異煙肼0.1g,3次/d或並用乙胺丁醇0.25g,3次/d。持續半年至1年
2.對無明確結核因素病例,可用中藥桂枝茯苓丸加清熱解毒藥物治療。
預後預防
預後:雖多年反覆發作健康狀況並不受影響,無明顯臟器受累症狀和體徵。
預防:
1.通過病因調查做好病因預防是預防本病的主要手段。
2.早診斷,早治療,儘可能尋找病原,進行對因治療。

